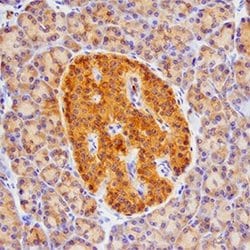
Invitrogen betacellulin Polyclonal Antibody 100 &mu;g | Buy Online | Invitrogen&trade; | Fisher Scientific

missing translation for 'onlineSavingsMsg'
Learn More
Learn More
Invitrogen™ betacellulin Polyclonal Antibody


Beschreibung
Reconstitute at 0.2 mg/mL in sterile PBS. Endoxin level is <0.10 EU per 1 μg of the antibody by the LAL method.
The protein encoded by this gene is a member of the EGF family of growth factors. It is synthesized primarily as a transmembrane precursor, which is then processed to mature molecule by proteolytic events. This protein is a ligand for the EGF receptor.

Spezifikation
Spezifikation
| Antigen | betacellulin |
| Anwendungen | Immunohistochemistry (Paraffin), Neutralization, Western Blot |
| Klassifikation | Polyclonal |
| Konzentration | 0.2 mg/mL |
| Konjugat | Unconjugated |
| Zusammensetzung | PBS with 5% trehalose and No Preservative |
| Gen | BTC |
| Gen-Zugriffsnummer | P35070 |
| Gen-Alias | Bcn; betacellulin; betacellulin, epidermal growth factor family member; BTC; OTTHUMP00000160600; OTTHUMP00000219057; Probetacellulin |
| Gensymbole | BTC |
| Mehr anzeigen |
Name des Produkts
Indem Sie auf Absenden klicken, erklären Sie sich damit einverstanden, dass Fisher Scientific sich mit Ihnen in Verbindung setzen kann, um Ihr Feedback in diesem Formular zu bearbeiten. Wir werden Ihre Informationen nicht für andere Zwecke weitergeben. Alle bereitgestellten Kontaktinformationen werden in Übereinstimmung mit unserer Datenschutzrichtlinie aufbewahrt. Datenschutzrichtlinie.
Haben Sie Verbesserungsvorschläge?